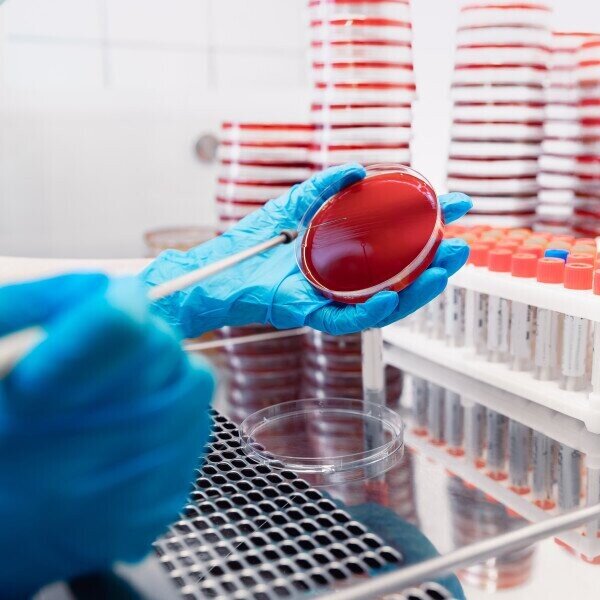

Precision and innovation combined
Now a new member of PHASE Scientific, ONCO Medical Laboratory capitalizes on the company's exceptional strengths in R&D and medical testing resources to deliver unparalleled support for women confronting health challenges. Our precise diagnostic tests and comprehensive follow-up services for gynaecology diseases guarantee the best possible health information for women.
For enquiry, please call 2783-8213, or email to info@onco.com.hk

A leader in gynaecology testing
ONCO Medical Laboratory exemplifies a steadfast commitment to excellence in gynecology testing services spanning over 30 years. Its high-quality pap smear tests and routine gynaecology tests have earned the unwavering trust of medical practitioners in Hong Kong. ONCO Medical Laboratory was accredited for HOKLAS ISO 15189:2012 since 2008 and currently one of the few laboratories in Hong Kong accredited for Pap test.

Empowering women's health with comprehensive support
ONCO Medical Laboratory have had a close partnership with PHASE Scientific since the COVID-19 outbreak. Together, we became the HKSAR Government's community testing contractor and provided over 8 million high-quality PCR tests for Hong Kong residents in the past three years. The acquisition allows us to combine the strengths of the two companies, and we are now well-positioned to provide the best possible support to women facing health challenges.
Our Services

HPV DNA Test
HPV DNA genotyping testing

STD / Microbial DNA Test
DNA testing for common vaginal infections
Cynaecology Culture Test
Bacterial culture testing for genital infection

BD SurePath Liquid-Based Pap Test
Advanced cytology test for cervical screening

